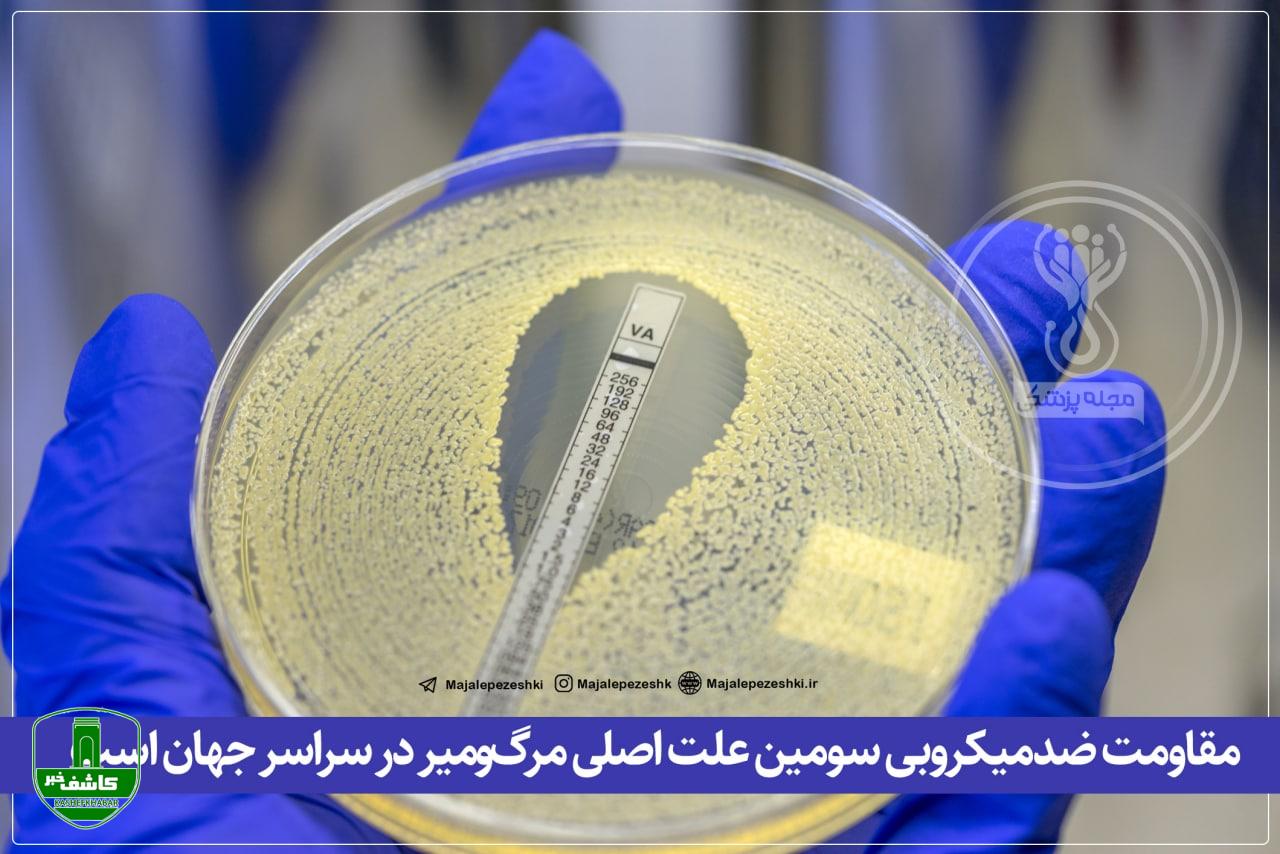

گروه : دستهبندی نشده

پژوهشگران با انجام تجزیهوتحلیلی نشان دادند که پس از سکتهی مغزی و بیماری قلبی، عاملی موجب مرگومیر انسانها میشود که ممکن است به آن فکر نکنید.
مقاومت آنتیبیوتیکی اغلب بهعنوان مشکلی برای آینده در نظر گرفته میشود؛ اما دادههای تازهمنتشرشده نشان میدهد که این مشکل هماکنون بیش از تصور شما بر زندگی مردم اثر میگذارد. درواقع، برآوردهای جدید نشان میدهد که در سال ۲۰۱۹، ۴/۹۵ میلیون مرگ مرتبط با مقاومت ضدمیکروبی باکتریایی رخ داده است
بدینترتیب،، مقاومت ضدمیکروبی سومین علت اصلی مرگومیر در سراسر جهان است.
- نصیبه جانی پور
- کد خبر 14501
- 120 بازدید
- بدون نظر
- پرینت
لینک کوتاه
https://kashefkhabar.ir/?p=14501